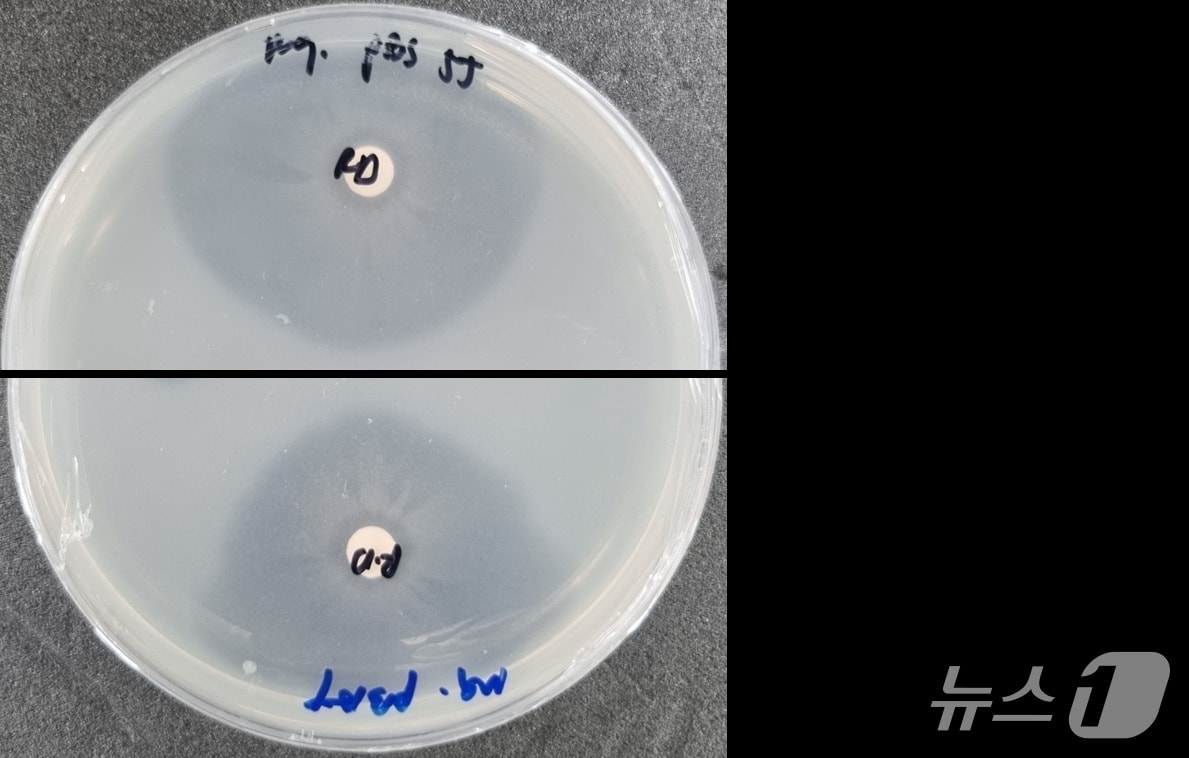
(기후부 제공) ⓒ 뉴스1

국내 토양서 플라스틱 15배 빨리 분해하는 미생물 발견
- 황덕현 기후환경전문기자
(세종=뉴스1) 황덕현 기후환경전문기자 = 기후에너지환경부 소속 국립생물자원관이 국내 토양에서 생분해성 플라스틱을 기존보다 15배 이상 빨리 분해하는 미생물을 찾아냈다. 이번 성과는 국내 자생 미생물을 활용해 플라스틱 폐기물 처리에 새로운 해법을 제시한 것으로 평가된다.
생물자원관은 2일 경북대 연구진과 공동 연구를 통해 국내 미기록 세균인 '로세아텔레스 디폴리머란스'(Roseateles depolymerans) 균주를 확보했다고 밝혔다. 이 균주는 농업용 필름이나 일회용 봉투에 쓰이는 생분해성 플라스틱인 PBS(폴리부틸렌숙신산염)와 PBAT(폴리부틸렌 아디페이트 테레프탈레이트)를 빠르게 분해하는 활성을 보였다.
실험에서 연구진은 해당 균주를 PBS 필름에 처리했을 때 10일 만에 74%가 원료 물질로 분해돼 미생물 성장에 이용되는 것을 확인했다. 이는 국제표준 ISO에서 제시한 분해 기간인 180일과 비교할 때 15~22배 빠른 속도다.
연구진은 관련 결과를 특허 출원했으며, 국제 학술지 '저널 오브 마이크로바이올로지 앤드 바이오테크놀로지'에 논문을 투고한 상태다.
ace@news1.kr
Copyright ⓒ 뉴스1. All rights reserved. 무단 전재 및 재배포, AI학습 이용금지.









